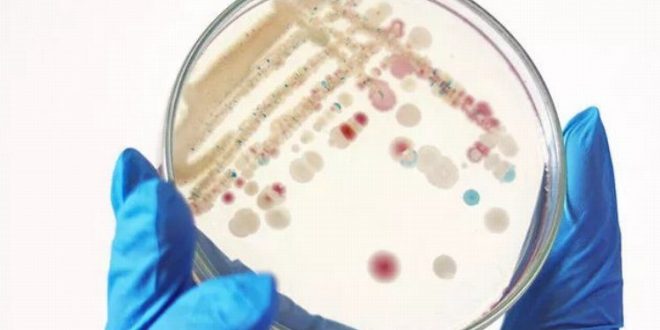
İngiltere’de ‘Strep A’ kabusu! 21'i çocuk 94 kişi hayatını kaybetti

İngiltere’de “Strep A” bakterisinin yol açtığı enfeksiyon nedeniyle 21’i çocuk, 94 kişi öldü.
İngiltere Sağlık Güvenliği Ajansı‘ndan (UKHSA), yapılan açıklamaya göre, ülkede 18 yaş altı 21 kişi, Strep A bakteriyel enfeksiyonu nedeniyle hayatını kaybetti.
Hastalık nedeniyle bugüne kadar yaşamını yitirenlerin sayısı 94’e çıktı.
Öte yandan 2017-2018 döneminde 27’si 18 yaş altı olmak üzere, 355 kişi bu bakteri nedeniyle ölmüştü.
Hastalığın görülme oranının önceki yıllara kıyasla daha yüksek
UKHSA, 6 Aralık’ta yaptığı açıklamada, ailelerin enfeksiyona karşı dikkatli olmaları uyarısında bulunarak antibiyotikle tedavi edilen hastalığın görülme oranının, önceki yıllara kıyasla daha yüksek olduğuna işaret etmişti.
Ajans, artışın büyük olasılıkla bakterinin toplum içinde yüksek miktarda dolaşımından kaynaklandığı tahmininde bulunmuştu.
Strep A bakterisi, genellikle insanların boğazına ve derisine yerleşerek zaman zaman soğuk algınlığı ve boğaz şişliğine yol açmasıyla biliniyor.
Vücudun bazı bölümlerinde kızarıklık ve deri enfeksiyonunun oluşmasına neden olan bakteriler, bazı vakalarda ciddi komplikasyonlara ve ölümlere yol açabiliyor.
Hastalığa sebep olan bakteri, hapşırma, öksürük ve yakın temas yoluyla insanlar arasında kolaylıkla yayılabiliyor.
 Mira Haber – Ortadoğu Bağımsız Muhabir Ajansı Tarafsız değiliz. Ancak Mirahaber'de sadece gerçekleri okursunuz.
Mira Haber – Ortadoğu Bağımsız Muhabir Ajansı Tarafsız değiliz. Ancak Mirahaber'de sadece gerçekleri okursunuz.